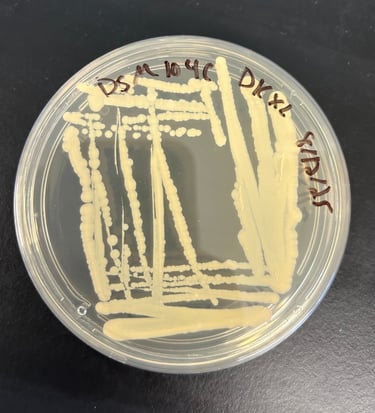

Microbial Ecology
Understanding microbial interactions in engineered systems

Microbial Ecology
Understanding microbial interactions in engineered systems
What we do
We characterize the microbial community in the bioreactor systems to study their composition, structure, and dynamics, and examine how these microbial populations interact with their physicochemical environment. Our work also investigates niche partitioning through spatial and temporal separation and the impact of product-induced toxicity on microbial function.
What we do
We characterize the microbial community in the bioreactor systems to study their composition, structure, and dynamics, and examine how these microbial populations interact with their physicochemical environment. Our work also investigates niche partitioning through spatial and temporal separation and the impact of product-induced toxicity on microbial function.
Approach

Approach







